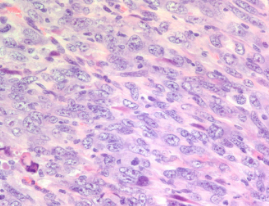

接触石棉是恶性间皮瘤的主要危险因素,恶性间皮瘤是一种侵袭性癌症,主要影响胸膜-衬里肺的组织-和腹膜-衬里腹部的组织。这已经知道了几十年了,但是间皮瘤的分子表征却鲜为人知,而且治疗选择也很少。西班牙国家癌症研究中心(CNIO)的研究人员针对此类癌症的关键分子过程进行了一项研究,确定了两种药物联合使用可有效对抗最具攻击性的间皮瘤。这些化合物已经在其他肿瘤的临床试验中使用,这一事实可能有助于加快对间皮瘤患者的研究。 此外,该研究的作者提出了一套用于预测治疗反应的分子标记,可用于确定哪些患者符合临床试验的条件。该研究由CNIO上皮癌变研究组负责人Paco Real和同一研究组的研究人员MiriamMarqués共同发表在《癌症研究》上。Paco Real说:“该研究结果具有相关性,因为间皮瘤尚未得到广泛研究,预后较差,没有针对性疗法。”“我们已经在小鼠和人类细胞系中发现了两种化合物的潜在功效的证据,这些化合物并不是全新的。现在,我们希望尽快开始进行临床试验。”间皮瘤-一种罕见的癌症在西班牙,每年有百万分之五的人死于间皮瘤。未来几年,该数字在该国和欧洲也可能会增加。间皮瘤通常被认为是职业病,是在工作场所接触石棉数十年之后发生的。在西班牙,石棉被广泛用于建筑业,尤其是在1960年代,直到2001年石棉被禁止作为潜在的健康危害。间皮瘤是一种相对罕见的癌症,因此,很少进行深入研究。间皮瘤中最具侵略性的类型称为肉瘤样癌,占病例的近25%。这类间皮瘤患者的生存时间为14至18个月。CNIO的上皮癌变研究小组所进行的研究正是针对肉瘤样间皮瘤。意外发现研究结果在很大程度上是出乎意料的。研究人员正在研究小鼠膀胱癌,主要研究两个抑癌基因:Pten和Trp53。令人惊讶的是,这些小鼠没有发展成膀胱癌,而是一种侵袭性的肉瘤样间皮瘤。(作者认为,鉴于这种侵袭性间皮瘤的快速发展,膀胱肿瘤没有时间发展。)为了寻找导致肿瘤细胞迅速扩散的分子原因,研究人员通过涉及GPCR家族蛋白的新机制,确定了MEK / ERK和PI3K途径的活性增强。用MEK和PI3Kbeta抑制剂阻断这些途径可降低小鼠间皮瘤细胞的增殖和侵袭能力。药物测试正在进行中接下来的步骤包括寻找能够抑制上述蛋白质并且已经在人体中进行测试的药物。这些药物是Selumetinib(一种MEK抑制剂)和AZD8186(一种靶向PI3Kbeta的分子)。用Paco Real的话说:“首先,我们在小鼠的肉瘤样间皮瘤中发现了改变的分子,然后我们验证了蛋白质在人的肉瘤样间皮瘤中也发生了改变,并找到了一种对小鼠和人类细胞系均有效的药物组合。我们选择了已经对其他人类肿瘤进行了测试的药物,因为它们的毒性已经广为人知,因此可以很快用于临床试验。”由于Pten和TP53是抑癌基因,而MEK和PIK3beta在许多其他人类肿瘤中显示出增强的活性,因此该发现可能与恶性间皮瘤以外的癌症类型有关。Marqués和Real也正在研究这种可能性。
此外,该研究的作者提出了一套用于预测治疗反应的分子标记,可用于确定哪些患者符合临床试验的条件。该研究由CNIO上皮癌变研究组负责人Paco Real和同一研究组的研究人员MiriamMarqués共同发表在《癌症研究》上。Paco Real说:“该研究结果具有相关性,因为间皮瘤尚未得到广泛研究,预后较差,没有针对性疗法。”“我们已经在小鼠和人类细胞系中发现了两种化合物的潜在功效的证据,这些化合物并不是全新的。现在,我们希望尽快开始进行临床试验。”间皮瘤-一种罕见的癌症在西班牙,每年有百万分之五的人死于间皮瘤。未来几年,该数字在该国和欧洲也可能会增加。间皮瘤通常被认为是职业病,是在工作场所接触石棉数十年之后发生的。在西班牙,石棉被广泛用于建筑业,尤其是在1960年代,直到2001年石棉被禁止作为潜在的健康危害。间皮瘤是一种相对罕见的癌症,因此,很少进行深入研究。间皮瘤中最具侵略性的类型称为肉瘤样癌,占病例的近25%。这类间皮瘤患者的生存时间为14至18个月。CNIO的上皮癌变研究小组所进行的研究正是针对肉瘤样间皮瘤。意外发现研究结果在很大程度上是出乎意料的。研究人员正在研究小鼠膀胱癌,主要研究两个抑癌基因:Pten和Trp53。令人惊讶的是,这些小鼠没有发展成膀胱癌,而是一种侵袭性的肉瘤样间皮瘤。(作者认为,鉴于这种侵袭性间皮瘤的快速发展,膀胱肿瘤没有时间发展。)为了寻找导致肿瘤细胞迅速扩散的分子原因,研究人员通过涉及GPCR家族蛋白的新机制,确定了MEK / ERK和PI3K途径的活性增强。用MEK和PI3Kbeta抑制剂阻断这些途径可降低小鼠间皮瘤细胞的增殖和侵袭能力。药物测试正在进行中接下来的步骤包括寻找能够抑制上述蛋白质并且已经在人体中进行测试的药物。这些药物是Selumetinib(一种MEK抑制剂)和AZD8186(一种靶向PI3Kbeta的分子)。用Paco Real的话说:“首先,我们在小鼠的肉瘤样间皮瘤中发现了改变的分子,然后我们验证了蛋白质在人的肉瘤样间皮瘤中也发生了改变,并找到了一种对小鼠和人类细胞系均有效的药物组合。我们选择了已经对其他人类肿瘤进行了测试的药物,因为它们的毒性已经广为人知,因此可以很快用于临床试验。”由于Pten和TP53是抑癌基因,而MEK和PIK3beta在许多其他人类肿瘤中显示出增强的活性,因此该发现可能与恶性间皮瘤以外的癌症类型有关。Marqués和Real也正在研究这种可能性。
此外,该研究的作者提出了一套用于预测治疗反应的分子标记,可用于确定哪些患者符合临床试验的条件。该研究由CNIO上皮癌变研究组负责人Paco Real和同一研究组的研究人员MiriamMarqués共同发表在《癌症研究》上。Paco Real说:“该研究结果具有相关性,因为间皮瘤尚未得到广泛研究,预后较差,没有针对性疗法。”“我们已经在小鼠和人类细胞系中发现了两种化合物的潜在功效的证据,这些化合物并不是全新的。现在,我们希望尽快开始进行临床试验。”间皮瘤-一种罕见的癌症在西班牙,每年有百万分之五的人死于间皮瘤。未来几年,该数字在该国和欧洲也可能会增加。间皮瘤通常被认为是职业病,是在工作场所接触石棉数十年之后发生的。在西班牙,石棉被广泛用于建筑业,尤其是在1960年代,直到2001年石棉被禁止作为潜在的健康危害。间皮瘤是一种相对罕见的癌症,因此,很少进行深入研究。间皮瘤中最具侵略性的类型称为肉瘤样癌,占病例的近25%。这类间皮瘤患者的生存时间为14至18个月。CNIO的上皮癌变研究小组所进行的研究正是针对肉瘤样间皮瘤。意外发现研究结果在很大程度上是出乎意料的。研究人员正在研究小鼠膀胱癌,主要研究两个抑癌基因:Pten和Trp53。令人惊讶的是,这些小鼠没有发展成膀胱癌,而是一种侵袭性的肉瘤样间皮瘤。(作者认为,鉴于这种侵袭性间皮瘤的快速发展,膀胱肿瘤没有时间发展。)为了寻找导致肿瘤细胞迅速扩散的分子原因,研究人员通过涉及GPCR家族蛋白的新机制,确定了MEK / ERK和PI3K途径的活性增强。用MEK和PI3Kbeta抑制剂阻断这些途径可降低小鼠间皮瘤细胞的增殖和侵袭能力。药物测试正在进行中接下来的步骤包括寻找能够抑制上述蛋白质并且已经在人体中进行测试的药物。这些药物是Selumetinib(一种MEK抑制剂)和AZD8186(一种靶向PI3Kbeta的分子)。用Paco Real的话说:“首先,我们在小鼠的肉瘤样间皮瘤中发现了改变的分子,然后我们验证了蛋白质在人的肉瘤样间皮瘤中也发生了改变,并找到了一种对小鼠和人类细胞系均有效的药物组合。我们选择了已经对其他人类肿瘤进行了测试的药物,因为它们的毒性已经广为人知,因此可以很快用于临床试验。”由于Pten和TP53是抑癌基因,而MEK和PIK3beta在许多其他人类肿瘤中显示出增强的活性,因此该发现可能与恶性间皮瘤以外的癌症类型有关。Marqués和Real也正在研究这种可能性。
此外,该研究的作者提出了一套用于预测治疗反应的分子标记,可用于确定哪些患者符合临床试验的条件。该研究由CNIO上皮癌变研究组负责人Paco Real和同一研究组的研究人员MiriamMarqués共同发表在《癌症研究》上。Paco Real说:“该研究结果具有相关性,因为间皮瘤尚未得到广泛研究,预后较差,没有针对性疗法。”“我们已经在小鼠和人类细胞系中发现了两种化合物的潜在功效的证据,这些化合物并不是全新的。现在,我们希望尽快开始进行临床试验。”间皮瘤-一种罕见的癌症在西班牙,每年有百万分之五的人死于间皮瘤。未来几年,该数字在该国和欧洲也可能会增加。间皮瘤通常被认为是职业病,是在工作场所接触石棉数十年之后发生的。在西班牙,石棉被广泛用于建筑业,尤其是在1960年代,直到2001年石棉被禁止作为潜在的健康危害。间皮瘤是一种相对罕见的癌症,因此,很少进行深入研究。间皮瘤中最具侵略性的类型称为肉瘤样癌,占病例的近25%。这类间皮瘤患者的生存时间为14至18个月。CNIO的上皮癌变研究小组所进行的研究正是针对肉瘤样间皮瘤。意外发现研究结果在很大程度上是出乎意料的。研究人员正在研究小鼠膀胱癌,主要研究两个抑癌基因:Pten和Trp53。令人惊讶的是,这些小鼠没有发展成膀胱癌,而是一种侵袭性的肉瘤样间皮瘤。(作者认为,鉴于这种侵袭性间皮瘤的快速发展,膀胱肿瘤没有时间发展。)为了寻找导致肿瘤细胞迅速扩散的分子原因,研究人员通过涉及GPCR家族蛋白的新机制,确定了MEK / ERK和PI3K途径的活性增强。用MEK和PI3Kbeta抑制剂阻断这些途径可降低小鼠间皮瘤细胞的增殖和侵袭能力。药物测试正在进行中接下来的步骤包括寻找能够抑制上述蛋白质并且已经在人体中进行测试的药物。这些药物是Selumetinib(一种MEK抑制剂)和AZD8186(一种靶向PI3Kbeta的分子)。用Paco Real的话说:“首先,我们在小鼠的肉瘤样间皮瘤中发现了改变的分子,然后我们验证了蛋白质在人的肉瘤样间皮瘤中也发生了改变,并找到了一种对小鼠和人类细胞系均有效的药物组合。我们选择了已经对其他人类肿瘤进行了测试的药物,因为它们的毒性已经广为人知,因此可以很快用于临床试验。”由于Pten和TP53是抑癌基因,而MEK和PIK3beta在许多其他人类肿瘤中显示出增强的活性,因此该发现可能与恶性间皮瘤以外的癌症类型有关。Marqués和Real也正在研究这种可能性。 





